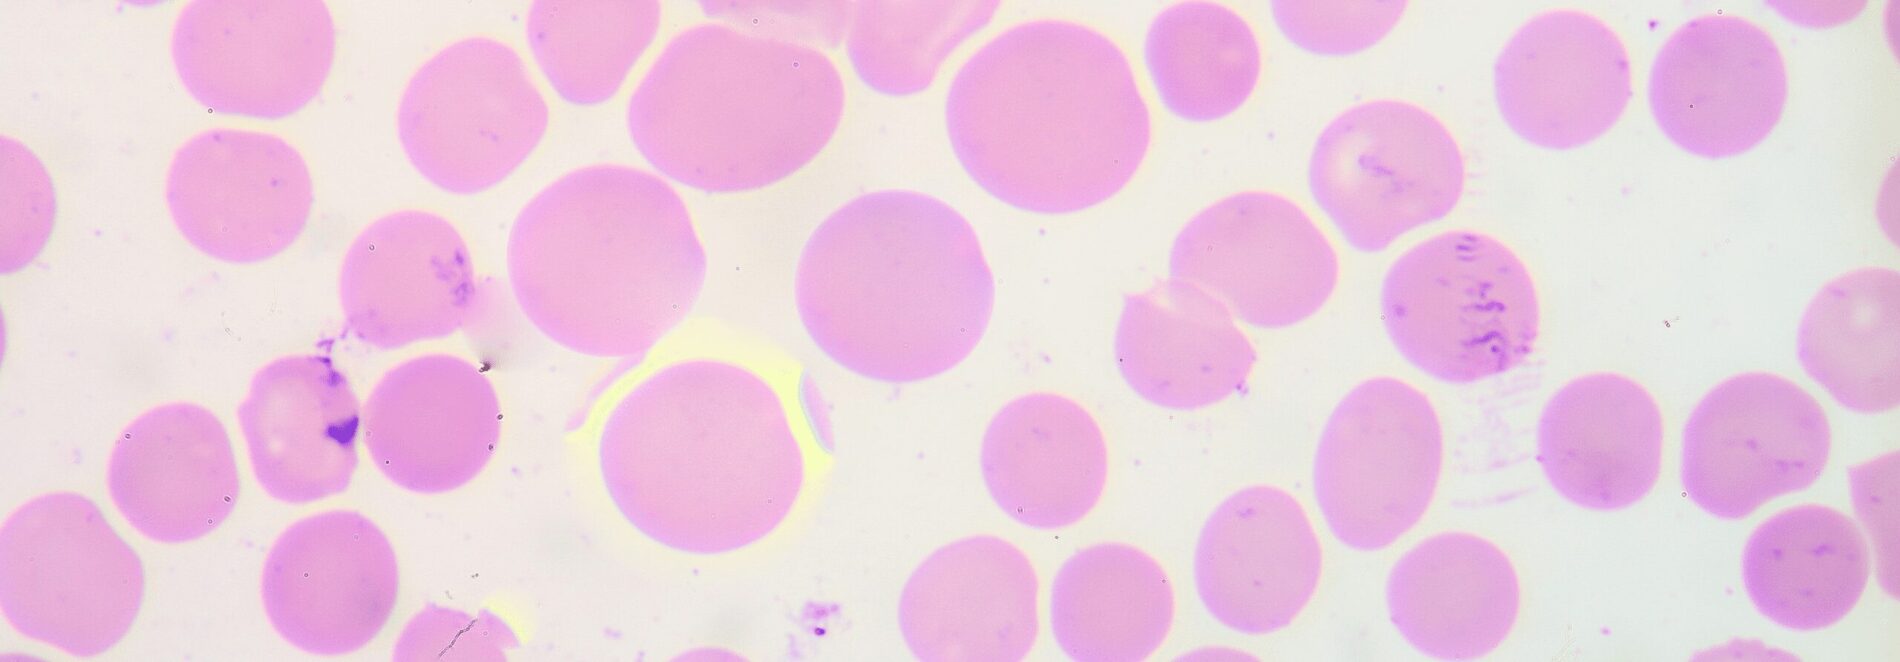
As Células Estaminais no Tratamento de Talassemias - 99

Gauri (nome alterado) foi diagnosticada com talassemia major, também conhecida como Anemia de Cooley, há 7 anos atrás na Índia, uma doença cuja única cura está no transplante de células estaminais da medula óssea ou do sangue do cordão umbilical de um dador saudável.
Infelizmente, tal como 70% da população da Índia, a menina não tinha um dador compatível na sua família. Os seus pais ansiaram que com o nascimento do seu irmão, em novembro de 2020, existiria uma nova esperança para a sua cura. Contudo, também o seu irmão não poderia ser o seu dador de células estaminais.
Gauri teve de procurar uma solução para além da sua família, sendo que foram utilizados registos internacionais na procura de um dador compatível. E finalmente, no Community Bank da LifeCell, a menina encontrou um dador de sangue do cordão HLA, 90% compatível.
Gauri foi assim submetida com sucesso ao seu transplante de sangue do cordão umbilical em maio de 2022, ganhando assim uma nova esperança na sua vida.
O que é talassemia?
A talassemia é um distúrbio hereditário que faz com que o corpo produza hemoglobina anormal, o componente dos glóbulos vermelhos que lhes permite transportar oxigénio.
As talassemias são classificadas de acordo com a cadeia de aminoácidos afetada. Os dois tipos principais são alfa-talassemia (a cadeia de globinas alfa é afetada) e beta-talassemia (a cadeia de globinas beta é afetada), sendo que estas podem posteriormente ser classificadas como menor, intermédia e maior, conforme a sua gravidade.
Todas as talassemias têm sintomas muito semelhantes, contudo podem variar consoante a sua gravidade, sendo os sintomas principais: anemia, fadiga, falta de ar, palidez, aumento do tamanho do baço, entre outros.